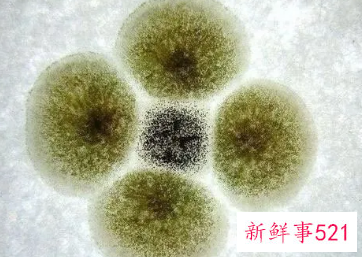
妇科病细菌感染是怎么来的

微信扫码关注
微信扫码关注看新鲜资讯

 微信扫码关注
微信扫码关注妇科病细菌感染是怎么来的
妇科病细菌感染是怎么来的,妇科细菌感染是在女性人群中经常发生的病症,大部分的女性都有着不同程度的妇科疾病,妇科疾病一旦患上再想去除就会非常麻烦。以下了解妇科病细菌感染是怎么来的
妇科病细菌感染是怎么来的1 1、外邪侵犯:以寒、湿、热邪为主(包括细菌、病毒),房事不节、产育过多、饮食失调、跌扑外伤等也可归纳在外因范围。女子以血为主,血得寒则凝滞,可出现月经后期、月经过少、痛经、闭经等病证;血热则妄行,可引起月经先期、月经过多、崩漏、经行吐衄等疾患;湿邪蕴热,夹热下注,易引发带下等病。
2、精神因素:人的精神情志(七情)变化可影响脏腑、气血的功能活动。精神情绪刺激,能影响冲任功能的调节,可致月经不调、闭经、痛经、经前乳胀、经行吐衄等症,所谓“因郁而致病”。此外,某些妇科慢性病,如崩漏、痛经、带下、癓瘕、不孕症等病证,久治不愈,亦可影响精神情绪变化,出现精神抑郁或情绪易于激动等现象,此即“因病而致郁”。
3、体质因素:是指素体虚弱的内在因素,主要是肾、肝、心、脾的功能失调,以致气血两虚、冲任不足、带脉不固。先天不足、肾精亏损,后天失调、脾胃虚损,大病久病之后气血亏虚,都可引起月经不调、闭经、痛经、带下、胎漏、不孕等症。
妇科病有哪些症状
1、阴道流血:出血部位可以是自阴道、宫颈、宫体等,但不论出血来自何处,除正常的月经外,都称为阴道流血。
2、白带异常:若出现阴道炎、宫颈炎或内生殖道组织癌变时,白带显著增多,性状改变或伴有臭味。
3、下腹痛:宫外孕、黄体破裂等急重症可致下腹痛,要引起足够重视。
4、外阴瘙痒:瘙痒常为阵发性发作,也可持续性,通常夜间加重。
5、下腹部包块:肿块可来自子宫或附件。
在这里小编要特别提醒一定,对于妇科病,千万不能讳疾忌医。只要发现自己的身体有所不适,即使内心的观念过不去,也一定要去及时就医。医生并不会有什么看法,因为你只是病人。如果患病之后一味拖延,只会让局势无法控制,千万注意。
妇科病细菌感染是怎么来的2 妇科细菌感染是什么引起的
1、不良的生活习惯
当女性在生活当中,长期的久坐不动、穿过紧的裤子、使用的卫生巾、护垫时间过长、不注重清理私密部位等,都会导致私密部位发生病菌滋生,私密部位在出现菌群失衡以后,便会容易导致妇科细菌感染,菌群失衡的出现,之后一系列的妇科炎症便会出现。
2、情绪异常
现代女性不仅需要忙于工作,还需要照顾家庭,在这双重压力之下,会导致身体内的激素水平发生失衡,容易造成内分泌失调的发生,这时候会导致女性私密部位对外界的抵抗能力会减弱,从而诱发私密部位病菌大量滋生与繁殖的现象。
3、生活环境病菌较多
女性在病菌比较多的环境下生活的时间较长,也会出现妇科细菌感染。比如让私密部位接触到尿液、粪便、病菌比较多的泳池、公共场所等,都会增加私密部位感染上病菌的几率。外源性病菌感染是引起妇科炎症的原因之一。
4、私密部位生理构造因素
女性的私密部位与男性的构造有所不同,病菌可以直接进入,受到阻碍也非常少。再加上私密部位环境过于密闭、阴暗,也给了病菌滋生提供了良好的'条件。女性在患上妇科炎症以后,细菌会顺着血管往上蔓延。
女性在生活中要养成良好的卫生习惯,在使用公共厕所时,要避免选择坐式马桶,在身体发生妇科细菌感染以后,也不要滥用抗生素药物,女性需要积极锻炼身体,保持均衡营养,不可以食用含糖量较高的食物。
妇科病细菌感染是怎么来的3 妇科病为什么反反复复
1、爱穿紧身裤
在现实生活中,有很多的女性为了展示自己的身材就经常穿紧身裤。但实际上经常穿紧身裤可能会导致我们的私密处不透气,很容易滋生病菌和毒素,这样是很容易引起妇科疾病的。经常穿紧身裤就会导致私处血液循环不畅通,导致细菌的感染,增加患上妇科疾病的几率。
2、爱憋尿
在现实生活中,由于工作压力越来越大,很多时候就会出现憋尿的情况。然而经常憋尿对于女性身体的伤害是很大的,这样就很有可能会造成膀胱增大,从而压迫子宫,这样就会对子宫产生很大的影响。而且经常憋尿就会导致体内的毒素不能及时排出去,就会引发很多的妇科疾病。并且有可能还会引发尿道炎、膀胱炎等,从而导致身体出现健康问题。
3、性生活不干净
很多时候女性阴道内的疾病是由男性的生殖道带进去的,肮脏的性就会导致外来细菌的进入。而残留在阴道内的细菌就会改变阴道的正常环境,导致炎症的复发。在日本研究人员表明,性引起妇科炎症的复发率高达90%,因此还是提醒大家性生活的时候一定要注意清洁卫生。
怎么让妇科病不再反复
1、多运动
妇科疾病是因为下体感染了细菌而导致的一种疾病,所以要避免炎症恶化还是需要提高身体抵御外部细菌的能力,也就是要提高自己的免疫力和抵抗力。而运动就是增加免疫力的很好的方式,运动出汗还能够排出体内的毒素,提高新陈代谢,在一定程度上会缓解炎症。
2、勤洗换内裤
内裤是贴身之物,内裤的干净卫生对于妇科是非常重要的。很多人觉得清洗内裤就是要高温消毒,但是高温只能够杀死一部分的细菌,最重要的还是要配合洗护产品。建议还是要买专门清洗内裤的洗护产品,可以更加彻底的清除内裤上的细菌,避免进一步感染。
推荐阅读

变态夫妻 · 雨夜绑架
# 变态夫妻 · 雨夜绑架## 一东京下雨,打湿巴黎。不对,东京下雨,打湿银座。市田贤一站在门口,抽着烟,看着雨幕里那辆慢慢开过来的白色轿车,嘴角勾起一抹笑。"来了。"他回头对屋里喊了一声,里面传来女人甜甜的声音:
2026-04-10

女人如雾
第001章·结婚多年,我和妻子之间的激情已经渐渐冷却。躺在床上,我叹口气感慨:「真希望还有一对夫妻跟咱们一起玩,那样就真的圆满了。」话刚说完我立刻警醒,脱口而出的话语让我心里后悔。因为害怕妻子好心情被我破坏
2026-04-10

NTR第一次体验白人年下小奶狗
外国小奶狗,很意外他才20岁还愿意去性病体检 刚好男友那时候在台湾我们三人在西门町星巴克聊不到10分钟就进房啦这局很有缘的约成了进房后他那双海般深邃的蓝眼睛 真的很喜欢彷彿带着某种禁忌的引力在对视的瞬间 就湿爆
2026-04-10

英国一女子一周内与双胞胎兄弟发生关系,后诞下一女,女儿
英国一女子一周内与双胞胎兄弟发生关系,后诞下一女,女儿8岁仍不知生父:日前,英国一家法院开庭审理了一起同卵双胞胎兄弟争当一名8岁女孩生父的案件,让法院为难的是,即使做了DNA鉴定,这对兄弟是那名女孩生父的可能
2026-04-10

可怜的西汉许皇后,不仅被废还被大臣骗财骗色,最后被皇帝
汉成帝后宫里的那抹白月光汉成帝刘骜这辈子见过的美女,大概比咱们这辈子见过的奶茶店还多。在他那莺莺燕燕的后宫里,许皇后原本是稳坐钓鱼台的正宫娘娘。许氏家族背景极其显赫,她的爷爷是大名鼎鼎的汉宣帝的岳父,
2026-04-10